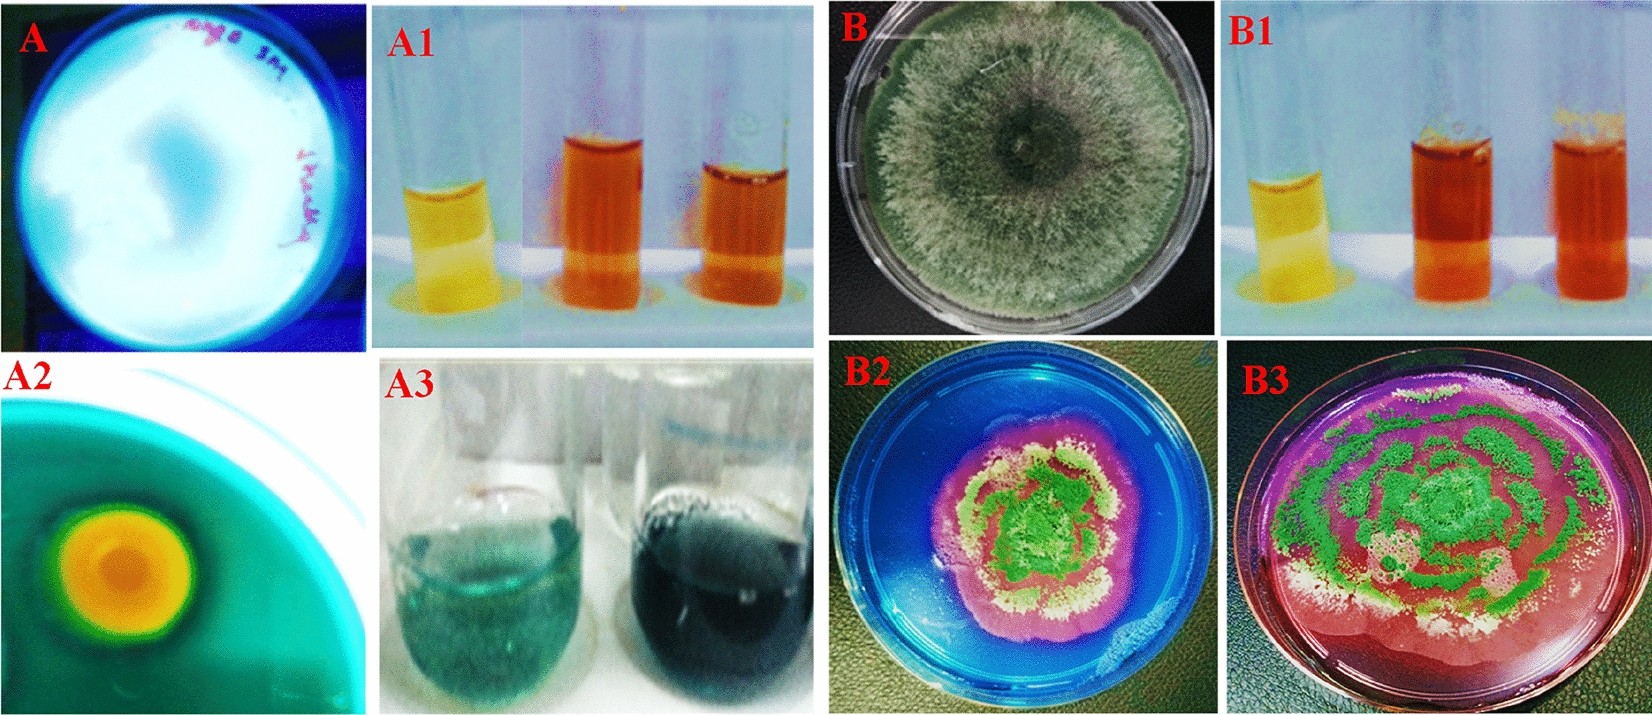
Figure 1

Figure 1
Pseudomonas PGPR-7 strain under UV light showing fluorescent (A). Ferric chloride (FeCl3) test indicating the production of siderophore (A1). Zone of halo formed by PGPR-7 strain on CAS gar plate (A2), and quantification of phenolate siderophore (A3). Trichoderma culture on PDA plate (B), FeCl3 test for siderophore production (B1). Panels B2 and B3 depicting the siderophore production ability of Trichoderma sp. T4.
